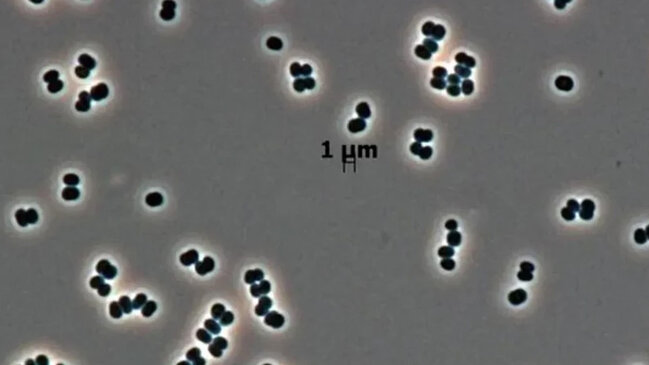

Kosmik agentliklər başqa planetlərə aparat göndərməzdən əvvəl “planetlərin qorunması” prinsipinə ciddi yanaşır. Məqsəd – “Yer mənşəli həyatın” başqa bir planetə daşınmasının və ya Yer-dən gələn “qaçaq sərnişinin” yanlışlıqla yeni həyat forması kimi qəbul edilməsinin qarşısını almaqdır. Bunun üçün bütün kosmik aparatların səthləri xüsusi şəraitdə sterilizasiya edilir. Lakin yeni tədqiqatlar göstərir ki, bəzi bakteriyalar bu sərt təmizlik prosedurlarından belə xilas ola bilir və bu hal həm planetlərarası araşdırmalar, həm də insan sağlamlığı üçün mühüm nəticələr doğura bilər.
Antarktida buzlaqlarından Yellouston geotermal sahələrinə qədər ekstremal şəraitdə yaşaya bilən ekstremofillər adlanan bakteriyalar əvvəldən məlum idi. Lakin insanlar, “kosmik aparatların təmiz otaqları” adlanan, süni şəkildə yaradılmış yeni bir ekstremal mühit formalaşdırıblar. Təmizlik prosedurları nə qədər ciddi olsa da, bəzi bakteriyalar sağ qalmaq üçün yeni strategiyalar inkişaf etdirir.
2007-ci ildə NASA-nın “Phoenix” eniş aparatının təmiz otağında aşkar edilən və əvvəllər yalnız Avropa Kosmik Limanında rast gəlinən “Tersicoccus phoenicis” bakteriyası bu “super orqanizmlərin” tipik nümunəsi sayılır. Tədqiqatçılar onun sterilizasiyadan xilas olmaq üçün “ölü kimi davranma” xüsusiyyətinə malik olduğunu müəyyən ediblər.
Bu bakteriyalar qida çatışmazlığı və quruluq kimi çətin şəraitdə “yuxu halına” keçərək sağ qalma qabiliyyətinə malikdir. Ən təhlükəli cəhət isə bu vəziyyətdə olarkən adi üsullarla aşkarlana bilməmələridir.
Houston Universitetindən mikrobioloq Madhan Tirumalai bu prosesi belə izah edir: “Onlar gizlənqaç oynayır. Uyğun şəraiti tapana qədər gizlənirlər”.
Tirumalai bu bakteriyaların bu şəkildə uzun müddət sağ qala bilməsinin və başqa planetlərə yayılma ehtimalının ciddi narahatlıq doğurduğunu bildirir.
Houston Universitetinin dəstəklədiyi araşdırmada alimlər “Micrococcus luteus” adlı yaxın bir növdən əldə edilən “Canlandırma Dəstəkləyici Faktorlar” (RPF) vasitəsilə bu “yuxuda” olan bakteriyaları yenidən aktivləşdirməyə nail olublar. Bu yuxu halının, hər il təxminən bir milyon insanın ölümünə səbəb olan vərəm bakteriyasını da əhatə edən “Actinobacteria” şüvəsinin ümumi xüsusiyyəti ola biləcəyi düşünülür.
Tədqiqatçılar bildiriblər ki, aşkar edilən bu canlandırıcı faktor təkcə “Tersicoccus”u deyil, həm də vərəm bakteriyasını aktivləşdirə bilir. Bu nəticə, vərəm bakteriyasının yuxu halına keçərək antibiotik müalicəsindən yayınma mexanizmini anlamaq baxımından mühüm addımdır.
Tirumalai, bu yuxu halının yalnız kosmik aparat təmiz otaqları ilə məhdudlaşıb-məhdudlaşmadığını da araşdırmaq istədiklərini qeyd edir:
“Əsas sual budur: bu yuxu halı xəstəxanalar, dərman zavodları və qida sənayesi kimi digər müəssisələrdə də mövcuddurmu?”
Bu bakteriyaların yayılma dərəcəsi müəyyən edildikdə, əldə edilən nəticələr digər sahələrdə də sağlamlıq risklərinin idarə olunmasına yardım edə bilər.
Mütəxəssislər bu bakteriyanın Marsa və ya Yupiter və Saturnun buzlu peyklərinə qədər yayıla biləcəyi ilə bağlı suala səmimi cavab verir: “Bilmirik”.
Bu qeyri-müəyyənlik həm həmin dünyalar haqqında bilik çatışmazlığından, həm də “Actinobacteria” şüvəsinin yuxu halı və davranışları barədə tam məlumata sahib olmamağımızdan irəli gəlir.
Tədqiqatın nəticələri göstərir ki, həm Yer üzündə ictimai sağlamlığa, həm də Günəş sisteminin dərinliklərində aparılan araşdırmalara təsirlərini tam anlamaq üçün əlavə elmi işlərə ehtiyac var.